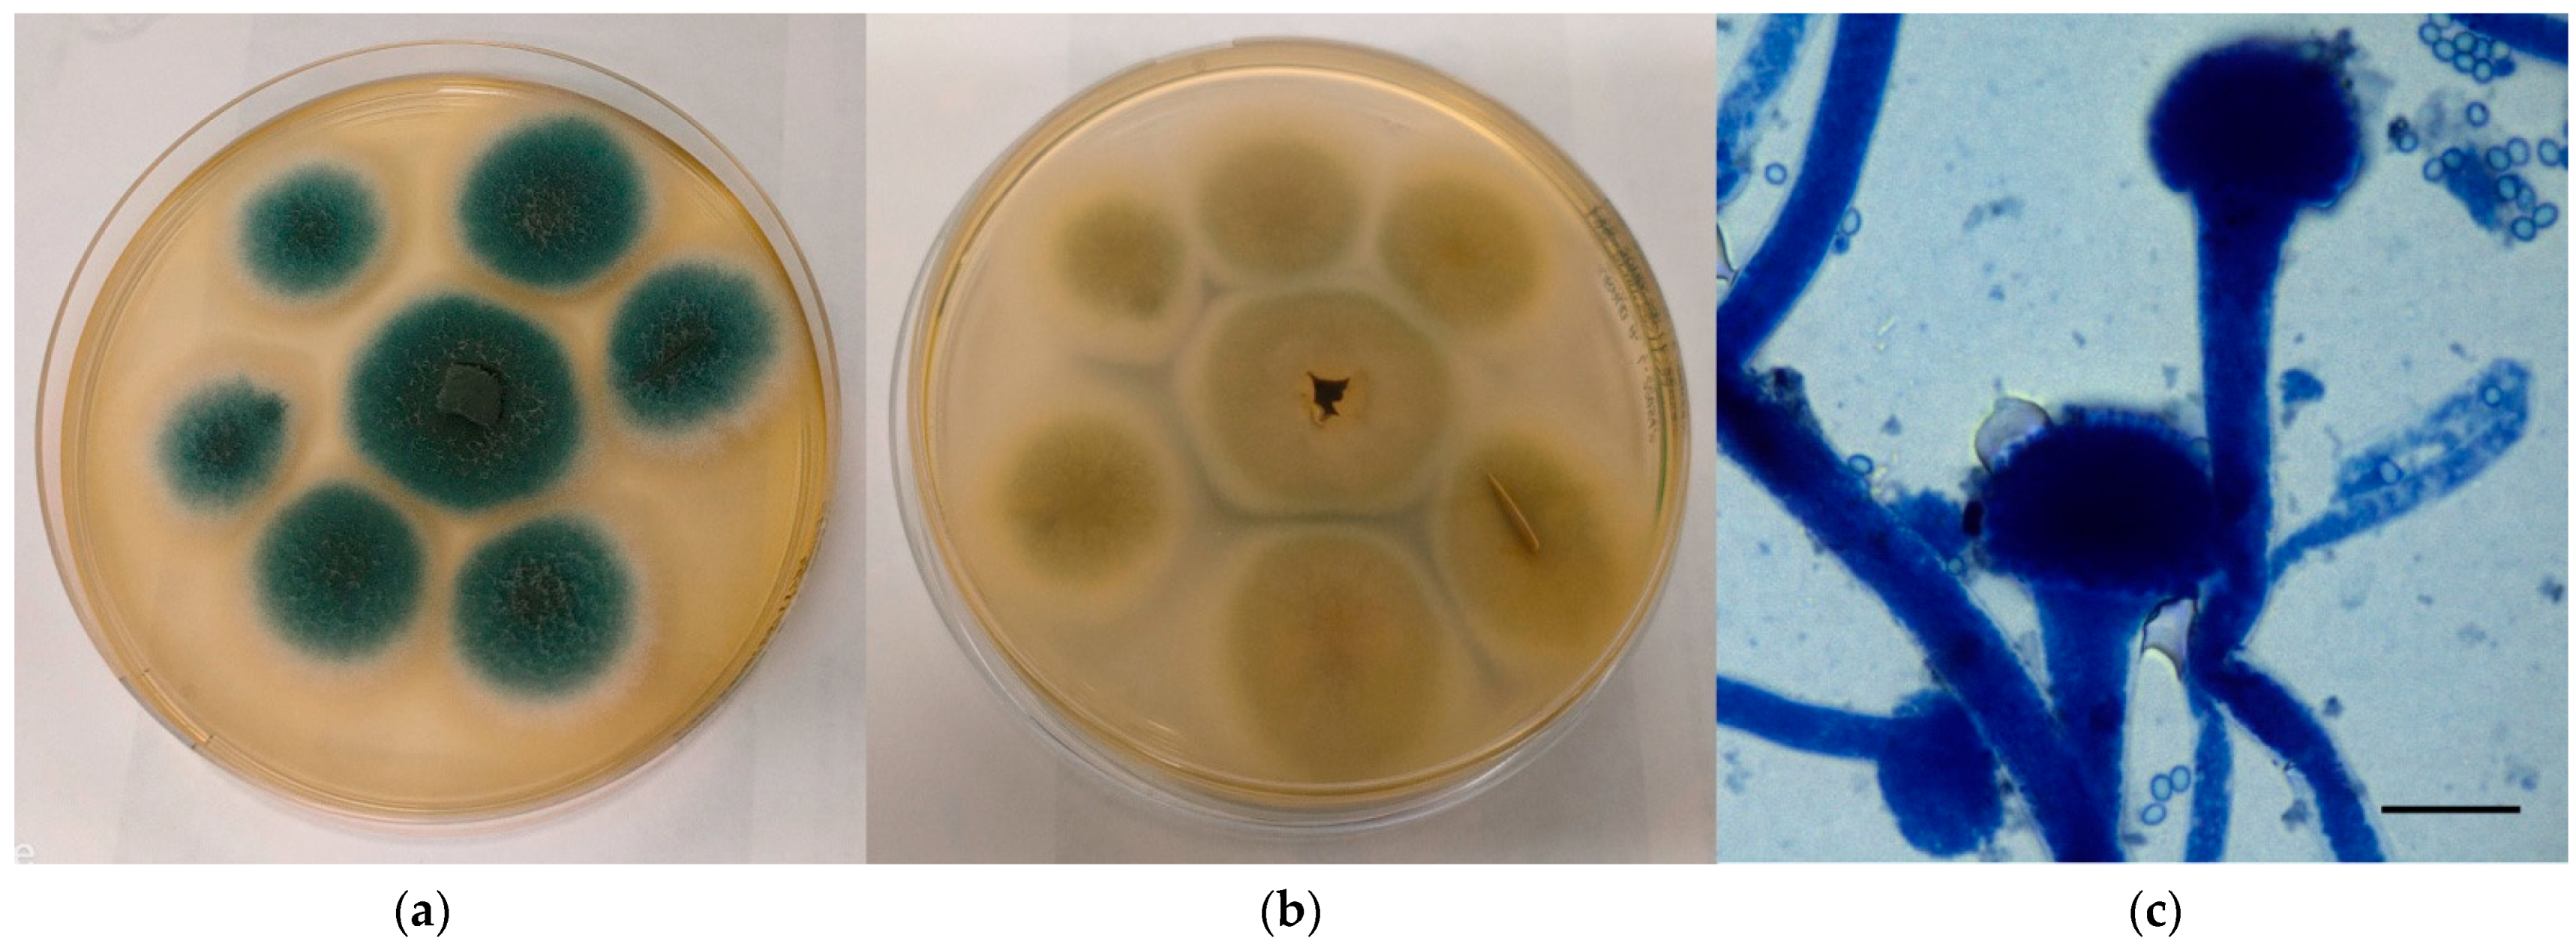
Jof 08 01213 g001 Jof 08 01213 g001
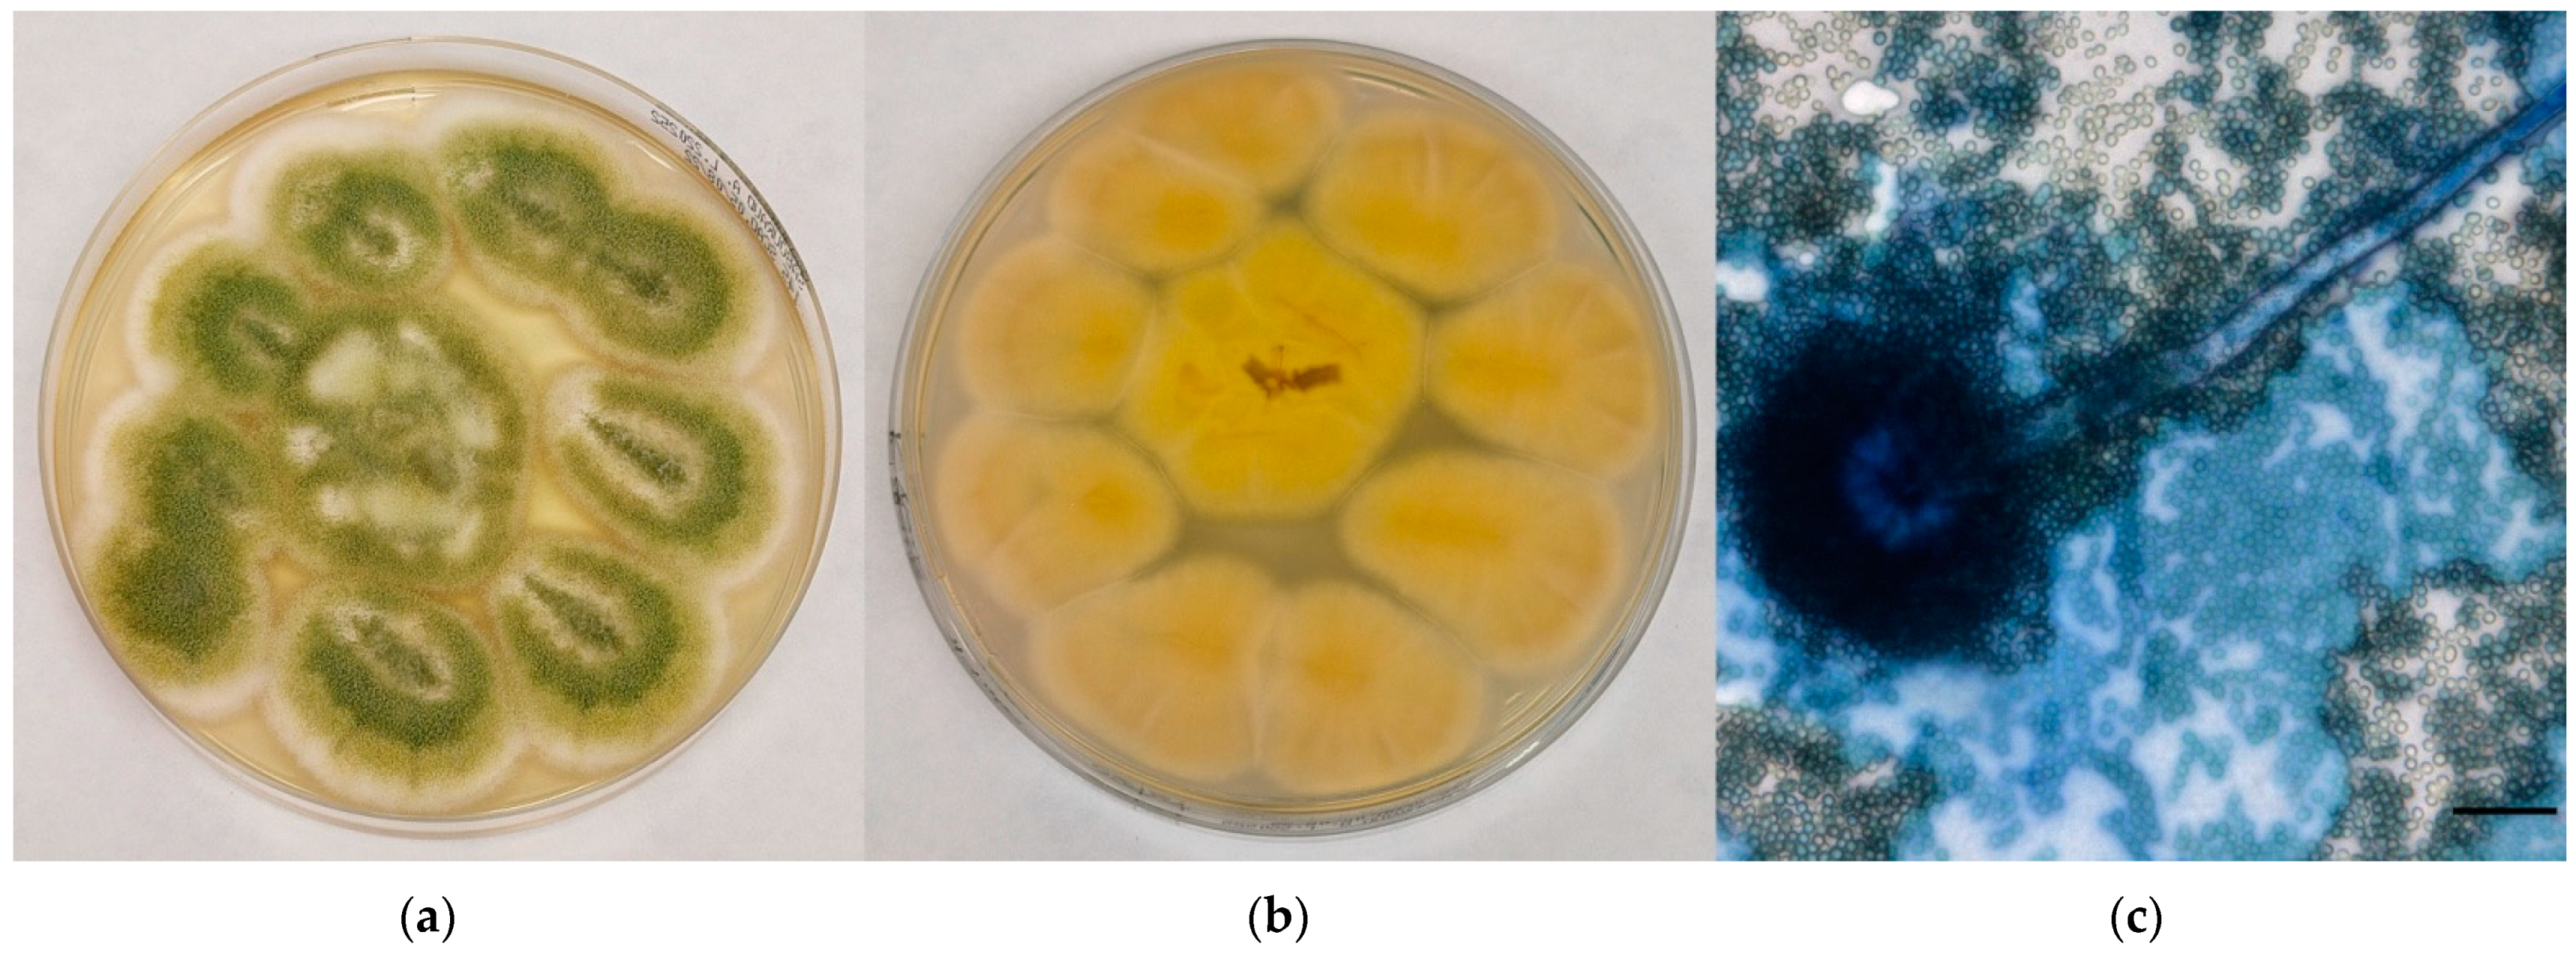
Jof 08 01213 g002 Jof 08 01213 g002

Preliminary Investigation about Aspergillus spp. Spread in Umbrian Avian Farms
Abstract
1. Introduction
2. Materials and Methods
2.1. Sampling
2.2. Isolation of Aspergillus spp.
2.2.1. Environmental Samples: Air and Surface Swabs
2.2.2. Environmental Samples: Litter, Soil, and Feed Samples
2.2.3. Animal and Human Samples
2.3. Identification of Aspergillus spp. and Evaluation of the Antifungal Resistance
2.4. Evaluation of the Presence of Mycotoxins in the Feed
2.5. Statistical Data Processing
3. Results
3.1. Isolation and Identification of Aspergillus spp. and Evaluation of The Antifungal Resistance
3.2. Evaluation of the Presence of Mycotoxins in Feed
4. Discussion
Supplementary Materials
Author Contributions
Funding
Institutional Review Board Statement
Informed Consent Statement
Data Availability Statement
Acknowledgments
Conflicts of Interest
References
- Tilavberdiev, S.A.; Denning, D.W.; Klimko, N.N. Serious Fungal Diseases in the Republic of Uzbekistan. Eur. J. Clin. Microbiol. Infect. Dis. 2017, 36, 925–929. [Google Scholar] [CrossRef]
- Brown, G.D.; Denning, D.W.; Gow, N.A.R.; Levitz, S.M.; Netea, M.G.; White, T.C. Hidden Killers: Human Fungal Infections. Sci Transl Med 2012, 4, 165rv13. [Google Scholar] [CrossRef]
- Murray, C.J.; Rosenfeld, L.C.; Lim, S.S.; Andrews, K.G.; Foreman, K.J.; Haring, D.; Fullman, N.; Naghavi, M.; Lozano, R.; Lopez, A.D. Global Malaria Mortality between 1980 and 2010: A Systematic Analysis. Lancet 2012, 379, 413–431. [Google Scholar] [CrossRef]
- Fisher, M.C.; Henk, D.A.; Briggs, C.J.; Brownstein, J.S.; Madoff, L.C.; McCraw, S.L.; Gurr, S.J. Emerging Fungal Threats to Animal, Plant and Ecosystem Health. Nature 2012, 484, 186–194. [Google Scholar] [CrossRef]
- Perea, S.; Patterson, T.F. Antifungal Resistance in Pathogenic Fungi. Clin. Infect. Dis. 2002, 35, 1073–1080. [Google Scholar] [CrossRef] [PubMed]
- Agarwal, R.; Chakrabarti, A.; Shah, A.; Gupta, D.; Meis, J.F.; Guleria, R.; Moss, R.; Denning, D.W. Allergic Bronchopulmonary Aspergillosis: Review of Literature and Proposal of New Diagnostic and Classification Criteria. Clin. Exp. Allergy 2013, 43, 850–873. [Google Scholar] [CrossRef] [PubMed]
- Denning, D.W.; Pleuvry, A.; Cole, D.C. Global Burden of Allergic Bronchopulmonary Aspergillosis with Asthma and Its Complication Chronic Pulmonary Aspergillosis in Adults. Med. Mycol. 2013, 51, 361–370. [Google Scholar] [CrossRef] [PubMed]
- Arné, P.; Thierry, S.; Wang, D.; Deville, M.; Le Loc’h, G.; Desoutter, A.; Féménia, F.; Nieguitsila, A.; Huang, W.; Chermette, R.; et al. Aspergillus Fumigatus in Poultry. Int. J. Microbiol. 2011, 2011, 1–14. [Google Scholar] [CrossRef] [PubMed]
- Beernaert, L.A.; Pasmans, F.; Van Waeyenberghe, L.; Haesebrouck, F.; Martel, A. Aspergillus Infections in Birds: A Review. Avian Pathol 2010, 39, 325–331. [Google Scholar] [CrossRef] [PubMed]
- Tell, L.A. Aspergillosis in Mammals and Birds: Impact on Veterinary Medicine. Med. Mycol. 2005, 43, 71–73. [Google Scholar] [CrossRef] [PubMed]
- Arcelli, R.; Moretti, A.; Tibaldini, P.; Mechelli, L.; Posteraro, B.; Moretta, I.; Agnetti, F. Micosi Rino-Sinusale in Un Cane Da Aspergillus Nidulans. In Proceedings of the IX Congresso Nazionale FIMUA, Catania, Italy, 27–29 November 2008. [Google Scholar]
- Sabino, R.; Faísca, V.M.; Carolino, E.; Veríssimo, C.; Viegas, C. Occupational Exposure to Aspergillus by Swine and Poultry Farm Workers in Portugal. J. Toxicol. Environ. Heal. Part A 2012, 75, 1381–1391. [Google Scholar] [CrossRef] [PubMed]
- Klich, M.A. Identification of Common Aspergillus Species; Centraalbureau voor Schimmelcultures: Utrecht, The Netherlands, 2002. [Google Scholar]
- Houbraken, J.; Kocsubé, S.; Visagie, C.M.; Yilmaz, N.; Wang, X.-C.; Meijer, M.; Kraak, B.; Hubka, V.; Bensch, K.; Samson, R.A.; et al. Classification of Aspergillus, Penicillium, Talaromyces and Related Genera (Eurotiales): An Overview of Families, Genera, Subgenera, Sections, Series and Species. Stud. Mycol. 2020, 95, 5–169. [Google Scholar] [CrossRef] [PubMed]
- Nasri, T.; Hedayati, M.T.; Abastabar, M.; Pasqualotto, A.C.; Armaki, M.T.; Hoseinnejad, A.; Nabili, M. PCR-RFLP on β-Tubulin Gene for Rapid Identification of the Most Clinically Important Species of Aspergillus. J. Microbiol. Methods 2015, 117, 144–147. [Google Scholar] [CrossRef] [PubMed]
- CLSI M61; Performance Standards for Antifungal Susceptibility Testing of Filamentous Fungi. 1st ed. CLSI: Wayne, PA, USA, 2017.
- CLSI M38; Reference Method for BrothDilution Antifungal Susceptibility Testing of Filamentous Fungi. 3rd ed. CLSI: Wayne, PA, USA, 2017.
- ISO 17025; General Requirements for the Competence of Testing and Calibration Laboratories. ISO: Geneva, Switzerland, 2017.
- ISO 21527-1; Microbiology of Food and Animal Feeding Stuffs—Horizontal Method for the Enumeration of Yeasts and Moulds. Part. 1: Colony Count Technique in Products with Water Activity Greater than 0,95. ISO: Geneva, Switzerland, 2008.
- ISO 18593; Microbiology of Food and Animal Feeding Stuffs—Horizontal Methods for Sampling Techniques from Surfaces Using Contact Plates and Swabs. ISO: Geneva, Switzerland, 2004.
- Bielawska-Drózd, A.; Cieślik, P.; Wlizło-Skowronek, B.; Winnicka, I.; Kubiak, L.; Jaroszuk-Ściseł, J.; Depczyńska, D.; Bohacz, J.; Korniłowicz-Kowalska, T.; Skopińska-Różewska, E.; et al. Identification and Characteristics of Biological Agents in Work Environment of Medical Emergency Services in Selected Ambulances. Int. J. Occup. Med. Environ. Health 2017, 30, 167. [Google Scholar] [CrossRef] [PubMed]
- Skóra, J.; Matusiak, K.; Wojewódzki, P.; Nowak, A.; Sulyok, M.; Ligocka, A.; Okrasa, M.; Hermann, J.; Gutarowska, B. Evaluation of Microbiological and Chemical Contaminants in Poultry Farms. Int. J. Environ. Res. Public Health 2016, 13, 192. [Google Scholar] [CrossRef] [PubMed]
- Mycology on Line. Available online: https://www.adelaide.edu.au/mycology/ (accessed on 20 October 2022).
- Wang, Y.; Chai, T.; Lu, G.; Quan, C.; Duan, H.; Yao, M.; Zucker, B.-A.; Schlenker, G. Simultaneous Detection of Airborne Aflatoxin, Ochratoxin and Zearalenone in a Poultry House by Immunoaffinity Clean-up and High-Performance Liquid Chromatography. Environ. Res. 2008, 107, 139–144. [Google Scholar] [CrossRef] [PubMed]
- Leonardelli, F.; Macedo, D.; Dudiuk, C.; Cabeza, M.S.; Gamarra, S.; Garcia-Effron, G. Aspergillus Fumigatus Intrinsic Fluconazole Resistance Is Due to the Naturally Occurring T301I Substitution in Cyp51Ap. Antimicrob. Agents Chemother. 2016, 60, 5420–5426. [Google Scholar] [CrossRef] [PubMed]
- Khan, M.S.A.; Ahmad, I. Antifungal Activity of Essential Oils and Their Synergy with Fluconazole against Drug-Resistant Strains of Aspergillus Fumigatus and Trichophyton Rubrum. Appl. Microbiol. Biotechnol. 2011, 90, 1083–1094. [Google Scholar] [CrossRef] [PubMed]
- Houbraken, J.; de Vries, R.P.; Samson, R.A. Modern Taxonomy of Biotechnologically Important Aspergillus and Penicillium Species. Adv. Appl. Microbiol. 2014, 86, 199–249. [Google Scholar] [PubMed]

| Farm/Tipology | Environmental Samples | Feed Samples | Animal Samples | Human Samples | Total Samples | |||
|---|---|---|---|---|---|---|---|---|
| Air Samples | Surface Samples | Litter Samples | Soil Samples | |||||
| A/i | 3 | 3 | 3 | 1 | 1 | 1 | 2 | 14 |
| B/i | 12 | 12 | 12 | 4 | 4 | 4 | 10 | 58 |
| C/i | 6 | 6 | 6 | 2 | 2 | 2 | 6 | 30 |
| D/i | 19 | 22 | 10 | 3 | 5 | 3 | 7 | 69 |
| E/r | 15 | 15 | 15 | 5 | 7 | 5 | 10 | 72 |
| F/i | 12 | 12 | 12 | 4 | 9 | 5 | 8 | 62 |
| G/i | 27 | 27 | 27 | 9 | 9 | 9 | 20 | 128 |
| H/i | 27 | 27 | 27 | 9 | 9 | 9 | 18 | 126 |
| Total samples | 121 | 124 | 112 | 37 | 46 | 38 | 81 | 559 |
| 394 | ||||||||
| Sample Category | Fungal Growth | Aspergillus spp. | A. fumigatus Complex | A. flavus Complex | A. niger Complex | No Fungal Growth | Total Samples |
|---|---|---|---|---|---|---|---|
| Environmental samples | 238 | 111 | 16 | 2 | 2 | 156 | 394 |
| Feed samples | 34 | 30 | 4 | 0 | 1 | 12 | 46 |
| Animal samples | 6 | 3 | 2 | 1 | 0 | 32 | 38 |
| Human samples | 20 | 18 | 4 | 2 | 0 | 61 | 81 |
| Total Aspergillus spp. | 162 (29%) | 26 (5%) | 5 (0.9%) | 3 (0.5%) | |||
| Total samples | 298 (53%) | 261 (47%) | 559 |
| Farm/Tipology | Aspergillus spp. Positive Samples | Total Samples/Farm | Prevalence | 95% CI |
|---|---|---|---|---|
| A/i | - | 14 | 0% | - |
| B/i | 11 | 58 | 19% | 10–31% |
| C/i | 13 | 30 | 43% | 25–63% |
| D/i | 26 | 69 | 38% | 26–50% |
| E/r | 20 | 72 | 28% | 18–40% |
| F/i | 19 | 62 | 31% | 20–44% |
| G/i | 46 | 128 | 36% | 28–45% |
| H/i | 27 | 126 | 21% | 15–30% |
| Total samples | 162 | 559 | 29% | 26–33% |
| Aspergillus Species | Strain | Sample Category | Sample Type | Accession Number | Overlap | Similarity | Probability |
|---|---|---|---|---|---|---|---|
| A. fumigatus | 1 | Environment | Air | CNRMA13.349 | 98.07% | 100.00% | 0 |
| 2 | Feed | Feed | CNRMA20.388 | 98.05% | 100.00% | 0 | |
| 3 | Animals | Lung | CNRMA13.349 | 98.25% | 100.00% | 0 | |
| 4 | Humans | Nasal swab | CNRMA20.141 | 99.37% | 100.00% | 0 | |
| A. flavus | 5 | Environment | Air | UOA/HCPF 8374A | 98.25% | 100.00% | 0 |
| 6 | Environment | Air | CBS 120.62 | 98.02% | 100.00% | 0 | |
| 7 | Animals | Lung | CBS 120.62 | 98.02% | 99.82% | 0 | |
| 8 | Humans | Nasal swab | CBS 119368 | 98.41% | 100.00% | 0 | |
| 9 | Humans | Nasal swab | CBS 119368 | 98.41% | 100.00% | 0 | |
| A. niger | 10 | Environment | Superficial swab | ITEM 11448 | 97.91% | 100.00% | 0 |
| 11 | Environment | Air | ITEM 10206 | 98.23% | 100.00% | 0 | |
| 12 | Feed | Feed | CNRMA13.330 | 98.23% | 99.64% | 0 |
| Antimycotic Drug | Number of Total Resistant Strains (%) | Number And Type of Resistant Strains | MIC Value |
|---|---|---|---|
| Anidulafungin | 6 (50%) | 3 A. fumigatus 3 A. flavus | 8 µg/mL 8 µg/mL |
| Micafungin | 6 (50%) | 3 A. fumigatus 3 A. flavus | 8 µg/mL 8 µg/mL |
| Caspofungin | 6 (50%) | 3 A. fumigatus 3 A. flavus | 8 µg/mL 8 µg/mL |
| 5-fluorocytosine | 8 (67%) | 2 A. fumigatus 4 A. flavus 2 A. niger | 32 µg/mL 64 µg/mL 32 µg/mL |
| Posaconazole | 1 (8%) | 1 A. niger | 4 µg/mL |
| Voriconazole | 2 (17%) | 2 A. niger | 2 µg/mL |
| Itraconazole | 3 (25%) | 2 A. fumigatus 1 A. flavus | 1 µg/mL 2 µg/mL |
| Fluconazole | 12 (100%) | 4 A. fumigatus 5 A. flavus 3 A. niger | 128µg/mL 64 µg/mL 64 µg/mL |
| Amphotericin B | 1 (8%) | 1 A. flavus | 4 µg/mL |
Publisher’s Note: MDPI stays neutral with regard to jurisdictional claims in published maps and institutional affiliations. |
© 2022 by the authors. Licensee MDPI, Basel, Switzerland. This article is an open access article distributed under the terms and conditions of the Creative Commons Attribution (CC BY) license (https://creativecommons.org/licenses/by/4.0/).
Share and Cite
Cruciani, D.; Crotti, S.; Maresca, C.; Pecorelli, I.; Verdini, E.; Rodolfi, M.; Scoccia, E.; Spina, S.; Valentini, A.; Agnetti, F. Preliminary Investigation about Aspergillus spp. Spread in Umbrian Avian Farms. J. Fungi 2022, 8, 1213. https://doi.org/10.3390/jof8111213
Cruciani D, Crotti S, Maresca C, Pecorelli I, Verdini E, Rodolfi M, Scoccia E, Spina S, Valentini A, Agnetti F. Preliminary Investigation about Aspergillus spp. Spread in Umbrian Avian Farms. Journal of Fungi. 2022; 8(11):1213. https://doi.org/10.3390/jof8111213
Chicago/Turabian StyleCruciani, Deborah, Silvia Crotti, Carmen Maresca, Ivan Pecorelli, Emanuela Verdini, Marinella Rodolfi, Eleonora Scoccia, Sara Spina, Andrea Valentini, and Francesco Agnetti. 2022. "Preliminary Investigation about Aspergillus spp. Spread in Umbrian Avian Farms" Journal of Fungi 8, no. 11: 1213. https://doi.org/10.3390/jof8111213
APA StyleCruciani, D., Crotti, S., Maresca, C., Pecorelli, I., Verdini, E., Rodolfi, M., Scoccia, E., Spina, S., Valentini, A., & Agnetti, F. (2022). Preliminary Investigation about Aspergillus spp. Spread in Umbrian Avian Farms. Journal of Fungi, 8(11), 1213. https://doi.org/10.3390/jof8111213

